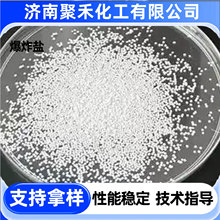
��ˮ��ը�}��Ư��ԭ��ϴ��ȥ�۝n��Чȥ�S���ׄ�������ˮ��ը�}

共 192件
彩漂粉原料
相關產品
所有類目
-
爆炸鹽廠家現貨彩色衣服去黃漂白劑除霉斑彩漂粉洗滌原料 爆炸鹽
山東 濟南市天橋區 -
現貨批發彩漂劑彩漂粉原料袋裝去污去黃去漬活氧彩漂粉
-
過氧碳酸鈉 彩漂粉洗衣機清洗劑洗滌劑爆炸鹽原料過氧碳酸鈉顆粒
-
過氧碳酸鈉 顆粒增氧水產養殖 彩漂粉爆炸鹽原料 過氧碳酸鈉
-
日化級彩漂粉原料去漬漂白助劑 彩漂劑生產用基礎原料彩漂粉原料
-
洗衣粉彩漂粉原料蛋白酶點綴物白色蛋白酶洗衣粉原料鹼性蛋白酶
-
批發鹼性蛋白酶點綴物去漬洗衣粉彩漂粉原料紅綠藍現貨活性蛋白酶
-
過氧碳酸鈉去污原料彩漂粉清洗去污劑爆炸鹽原料過氧碳酸鈉顆粒
-
彩漂粉洗衣粉原料酒店旅館家用增白去污洗滌原料彩漂粉
-
散裝彩漂粉 酒店用去污去漬爆炸鹽 去黃增白洗衣粉彩漂粉原料
-
冷水速溶彩漂粉顆粒洗衣彩漂去黃 金科宏業過氧碳酸鈉 爆炸鹽原料
-
爆炸鹽原料批發彩漂粉去污漂白劑衣物去漬去黃用顆粒工業級
-
批發輕質硅酸鈉 洗衣粉母料彩漂粉爆炸鹽校服凈原料 輕質硅酸鈉
-
廠家現貨彩漂粉原料 衣物通用去黃去漬袋裝留香高含量 彩漂粉
-
現貨批發彩漂粉爆炸鹽原料洗衣洗滌去污漬增白增艷散裝彩漂粉
-
爆炸鹽原料去油不去色干洗店酒店漂白劑洗滌去污力強 彩漂粉
-
彩漂粉顆粒爆炸鹽原料增白去污漂白去黃去污酒店爆炸鹽彩漂粉去漬
-
億勤現貨藍色四乙酰乙二胺 綠色TAED彩漂粉原料一公斤起量大含運
-
彩漂粉洗衣粉原料酒店家用增白去污增艷衣物洗滌爆炸鹽原料彩漂粉
-
冷水爆炸鹽彩漂粉原料洗衣去污漬高效去黃增白劑速溶冷水爆炸鹽
-
爆炸鹽原料過碳彩漂粉漂白去污去黃去漬洗滌泡泡粉彩漂粉原料
-
彩漂粉廠家批發 速溶增白去污去油洗滌原料 工業洗滌助劑彩漂粉
-
彩漂粉洗衣房賓館酒店散裝洗衣粉原料廠家現貨去漬去油活性氧漂粉
-
過碳洗衣粉彩漂粉袋裝活氧彩漂劑去黃去漬洗滌泡泡粉彩漂粉原料
-
彩漂粉彩漂原料粉干洗店酒店彩漂洗滌衣物去油污散裝 彩漂粉
-
彩漂粉洗衣粉原料酒店旅館家用去污散裝衣物洗滌彩漂粉
-
彩漂粉原料衣物漂白去除異味活氧去污粉原料去漬去黃彩漂粉原料
-
爆炸鹽原料碳酸鈉顆粒漂白彩漂粉洗滌原料 過氧碳酸鈉顆粒
-
爆炸鹽彩漂粉活氧泡泡粉管道疏通劑各種清潔劑原料冷水爆炸鹽原料
-
爆炸鹽原料現貨去油不去色干洗店酒店漂白劑洗滌去污力強 彩漂粉
-
洗衣機槽清潔劑原料茶銹除垢小白鞋彩漂粉過氧碳酸鈉洗衣機清洗劑
-
花香爆炸鹽 去霉去污去漬增白泡泡粉彩漂粉爆炸鹽原料
-
鹼性蛋白酶去血漬奶漬污漬彩色蛋白酶洗衣粉原料鹼性蛋白酶
-
過氧碳酸鈉 現貨去黃去漬大袋散裝彩漂粉漂白洗滌原料過氧碳酸鈉
-
過氧碳酸鈉顆粒爆炸鹽原料彩漂粉河南宏業去污增白洗滌原料爆炸鹽
-
過氧碳酸鈉原料各種洗滌劑粉劑泡立凈彩漂粉洗衣機槽清潔劑爆炸鹽
-
鹼性蛋白酶洗滌劑彩色粒子紅藍綠洗衣粉彩色粒子彩漂粉原料批發
-
過碳洗衣粉彩漂粉清洗劑洗滌劑去黃去漬洗滌彩漂粉原料
-
生物酶現貨洗衣粉點綴酶洗滌原料生物酶彩漂粉紅藍綠酶
-
鹼性蛋白酶洗衣粉爆炸鹽彩漂粉洗衣液原料液體蛋白酶去漬無磷